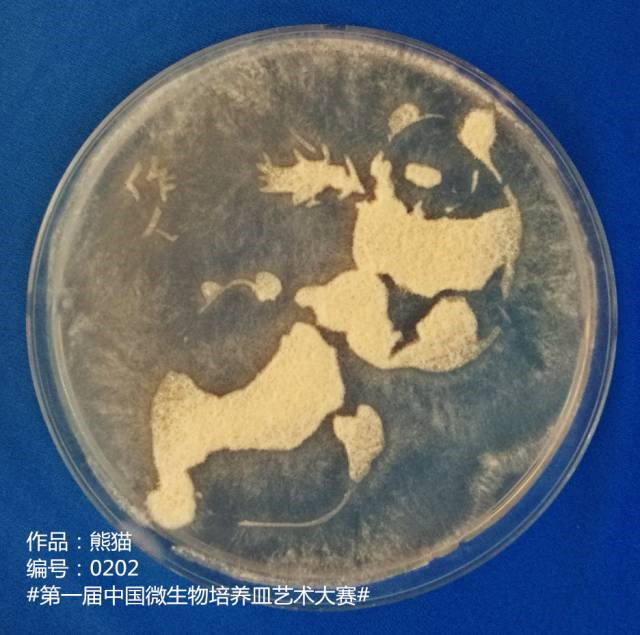
老外用细菌绘《蒙娜丽莎》中国科学家用微生物

用细菌绘蒙娜丽莎 意大利科学家用百万细菌绘
506x341 - 21KB - JPEG

老外用细菌绘《蒙娜丽莎》中国科学家用微生物
640x641 - 224KB - JPEG

老外用细菌绘《蒙娜丽莎》中国科学家用微生物
640x570 - 223KB - JPEG

震惊!科学家用百万细菌绘《蒙娜丽莎》,显微镜
441x734 - 68KB - JPEG

震惊!科学家用百万细菌绘《蒙娜丽莎》,显微镜
880x1311 - 133KB - JPEG

震惊!科学家用百万细菌绘《蒙娜丽莎》,显微镜
431x600 - 38KB - JPEG

震惊!科学家用百万细菌绘《蒙娜丽莎》,显微镜
690x826 - 72KB - JPEG

惊艳!科学家用100万活细菌绘蒙娜丽莎 令人惊
553x299 - 25KB - JPEG

老外用细菌绘《蒙娜丽莎》中国科学家用微生物
640x597 - 182KB - JPEG

老外用细菌绘《蒙娜丽莎》中国科学家用微生物
630x783 - 489KB - JPEG

震惊!科学家用百万细菌绘《蒙娜丽莎》,显微镜
500x619 - 69KB - JPEG

震惊!科学家用百万细菌绘《蒙娜丽莎》,显微镜
640x449 - 28KB - JPEG

震惊!科学家用百万细菌绘《蒙娜丽莎》,显微镜
625x932 - 112KB - JPEG
老外用细菌绘《蒙娜丽莎》中国科学家用微生物
640x635 - 240KB - JPEG

震惊!科学家用百万细菌绘《蒙娜丽莎》,显微镜
600x736 - 102KB - JPEG
原标题:意大利科学家用百万细菌“绘制”《蒙娜丽莎》[环球网科技综合报道]2018年8月21日讯(具体拍摄时间
这幅使用细菌“绘”成的《蒙娜丽莎》,是由意大利罗马的一个研究小组还原那么,研究小组为何会用细菌绘制这
来自意大利罗马的一个研究小组还原了名画作《蒙娜丽莎》,该作品由一百万对光敏感的大肠杆菌形成,需要用
用细菌绘蒙娜丽莎?意大利科学家完成新“杰作”(2),原标题:意大利科学家用百万细菌绘制《蒙娜丽莎》[环球
用细菌绘蒙娜丽莎怎么回事?为什么用细菌绘蒙娜丽莎?用细菌绘蒙娜丽莎怎么回事?为什么用细菌绘蒙娜丽莎?
用细菌绘蒙娜丽莎,意大利科学家用百万细菌绘蒙娜丽莎过程曝光十分难以想象。来自意大利罗马的一个研究小组
除了名画作《蒙娜丽莎》外,该研究小组还利用细菌绘制了科学家爱因斯坦和达尔文的肖像画。
除了名画作《蒙娜丽莎》外,该研究美国著名杂志《纽约客》使用了“莱温斯基版蒙娜丽莎”作为杂志封面,引起